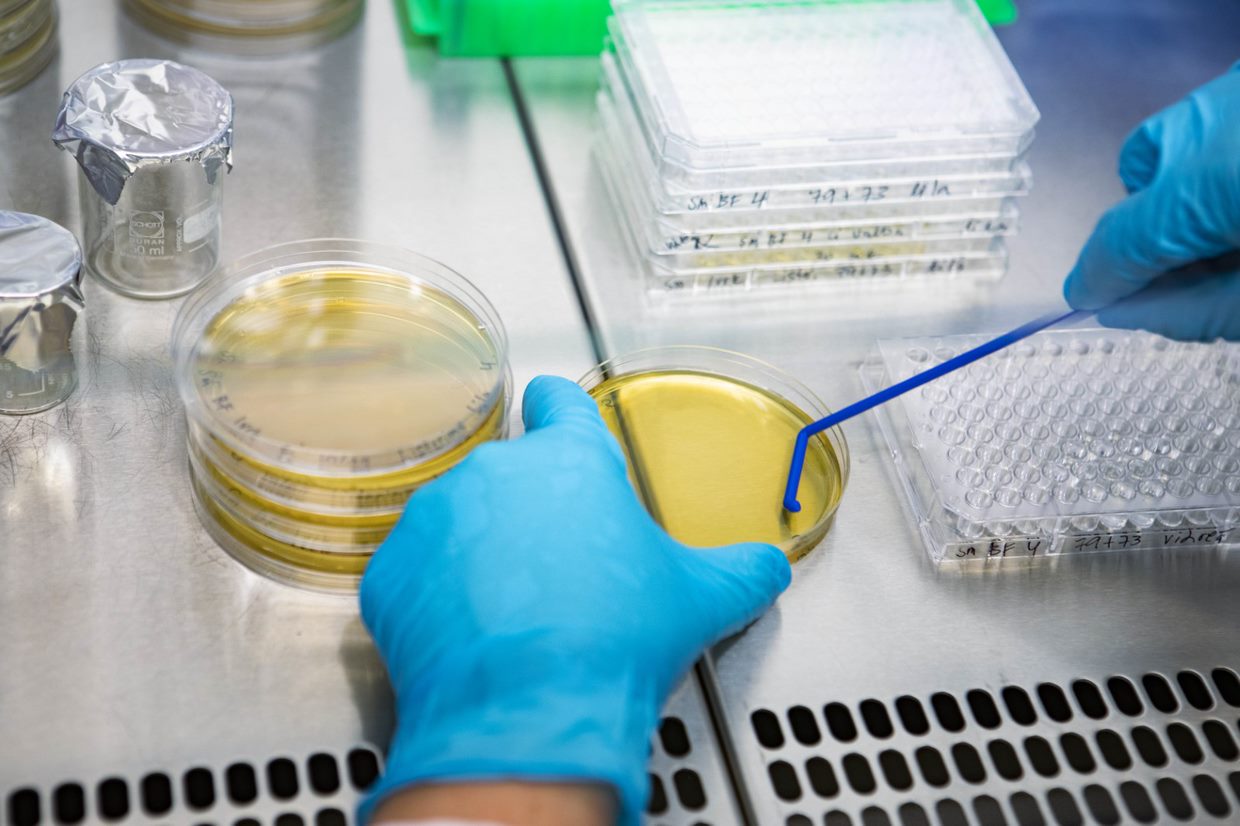
Mikon tarina: Työ Lumoral-tutkimuksen parissa auttaa ratkomaan maailman hammasterveyden haasteita

- Kaikki viestit
- 8 Media Ventures
- Aaltoyliopisto
- Ääntäminen
- ADHD
- Aivoinfarkti
- Aivoterveys
- Aivoverenkiertosairaus
- Alternative antimicrobial therapy
- Alzheimerin tauti
- aMMP-8
- Annimari Korte
- Antibacterial photodynamic therapy
- Antibioottiresistenssi
- Apotek Hjärtat
- Apteekkijakelu
- aquadental
- Asiakkaiden kokemuksia
- Bakteremia
- BESS
- Biofilm
- Biologiset lääkkeet
- Bonnier
- Bonnier News
- British Dental Journal
- Business Finland
- Chronin tauti
- Croatia
- Deloitte
- dementia
- Dentex
- Diabetes
- Dual-light therapy
- Duodecim
- EFP
- elinsiirtopotilaat
- Elokuva
- Erja Nuutinen
- Esiintyminen
- Espanja
- EuroPerio
- FIBO
- Fonetiikka
- Halitoosi
- ham
- hammaseroosio
- Hammaskivi
- Hammaslääkäripäivät
- hammaslääkäripelko
- hammaslääketiede
- Hampaasi
- Hampaiden puhdistus
- Hampaiden reikiintyminen
- health tech
- HealthHub Pharma
- Henkinen hyvinvointi
- Henkisyys
- huippu-urheilu
- IBD
- IDS
- Ientulehdus
- ikäihminen
- iloveme
- implantti
- Implanttihoito
- Infektiot
- Intia
- investment
- Investointi
- Itseluottamus
- jäätee
- Jakelukumppanuus
- Jakelusopimus
- Jooga
- Jordan
- julkinen terveydenhoito
- juoksu
- Kansainvälinen ienterveyspäivä
- karies
- kasvisruoka
- kilpaurheileminen
- Kirja
- Klooriheksidiini
- Koite Health
- Koite Helath
- Koko Suomi harjaa
- Koliitti
- Kongressitapahtuma
- Kotihammas
- LaHanna
- Lasten hammashoito
- Latvia
- Laulaminen
- leikkauspotilaat
- lemmikit
- lentopallo
- Liettua
- Lumoral
- Lumoral app
- Lumoral Junior
- Lumoral-asiakastapahtuma
- Lumorinse
- Maailman Alheimer-päivä
- Maailman diabetespäivä
- Maailman hymypäivä
- Maailman kariesvapaa tulevaisuus
- Maailman luovuuden ja innovaatioiden päivä
- Maailman ruokapäivä
- Maailman Suunterveyspäivä
- Maailman sydänpäivä
- Maailman syöpäpäivä
- Maailman terveyspäivä
- Maailman tupakoimattomuuspäivä
- Maailman tupakoimattomuuspäivää
- Meditaatio
- MegaGen
- Merenkulkijanpäivä
- messukeskus
- Metropolia-amk
- mikrobitasapaino
- Motivoiva haastattelu
- muistisairaus
- Murrosikä
- musiikki
- Naistenpäivä
- nikotiini
- Nokian Kumiväen Sairauskassa
- Nukutushammashoito
- nuoret
- Oikomishoito
- olympialaiset
- Osakeanti
- Pahanhajuinen hengitys
- Parodontiitti
- Patentti
- Peri-implant disease
- Peri-implantiitti
- PH-arvo
- Photodynamic therapy
- Pitkäaikaissairaus
- Plakki
- polkuhuoksu
- Polkujuoksu
- potilasturvallisuus
- Psoriasis
- Punajäkälä
- Puola
- QAdental
- R&D
- Raikas hengitys
- Raskaus
- Ravintoaineet
- Rockmusiikki
- Rokkari
- Romania
- Roomchang
- Ruokailu
- Ruotsi
- Sairaalahoito
- Saksa
- Seksuaalisuus
- Sepsis
- Sijoittaminen
- Sisarukset-elokuva
- Sjögren
- Soft-tissue infections
- Sosiaalinen media
- Sponsorointi ja Tapahtumat Awards
- Staphylococcus aureus
- startup
- Streptococcus oralis
- Streptococcus viridans
- suolistosairaudet
- Suolistosyöpä
- Suomen Suuhygienistiliitto
- Suuhygienia
- suuhygienisti
- suuhygienistiliitto
- Suun mukosiitti
- Suun terveys
- suunterveys
- Suuvesi
- Swed Green Group
- Sydänterveys
- Syöpä
- Tanska
- Tapahtuma
- Tech Tour 2022
- terveys
- terveysteknologia
- Thaimaa
- Tiede
- toimenpidepelko
- triathlon
- Tupakointi
- Tutkimus
- tutkimushoitajat ry
- Ultrajuoksu
- uni
- Unioni45
- Urheilu
- UTMB
- Uutiset
- Vaihdevuodet
- valkaisuhoito
- vanhustenviikko
- vegaani
- Venrenpaine
- Viro
- Von Hertzen Brothers
- vuoden suuhygienisti
- Webinaari
- white cross
- WHO
- Yhdysvallat
- Yhteistyösopimus
- yleislääketiede
- Yleisterveys
- Ystävänpäivä
- Ystävyyssuhteet

Valoaktivoitava hoito tehostaa peri-implanttikudosten omahoitoa
Hammasimplanttien kestävyys on usein erinomainen ja asennusten onnistumisprosentti korkea. Ongelmia kuitenkin myös esiintyy, ja tulehdus implantin ympärillä olevissa kudoksissa on tavallista. Ylein...
Mikon tarina: Työ Lumoral-tutkimuksen parissa auttaa ratkomaan maailman hammasterveyden haasteita
Aloitin mielenkiintoisen työn Lumoralin parissa maaliskuussa 2022 kliinisen tutkimuksen asiantuntijana. Lumoral-hoito on varsin uusi hampaiden itsehoitomuoto, joka on jo alustavissa tutkimuksissa* ...

Lumoral-terveysteknologia esillä Tampereen Tutkimushoitajapäivillä
Koite Health on kutsuttu kaksipäiväisille Tutkimushoitaja- ja tutkimuskoordinaattoripäiville esittelemään antibakteeriseen kaksoisvalohoitoon perustuvaa Lumoral-laitetta. Tutkimushoitajat ry;n puh...

Lumoralista apu muistisairaan potilaan iensairauteen
Huolellinen hampaiden omahoito on perusta iensairauksien kuten parodontiitin ennaltaehkäisyssä ja hoidossa. Tehokas mekaaninen hampaiden harjaus ja lankaus ei kuitenkaan aina riitä. Esimerkiksi iäk...

Lumoral mediassa: Koite Health kasvaa Kilosta maailmalle – Länsiväylä
Suomalaisten hampaat ovat yhä huonommassa kunnossa ja julkinen terveydenhoito on kriisissä. Lumoral-hoidosta voi olla apua molempiin, kirjoittaa kaupunkilehti Länsiväylä. Lumoral-laitteella voitai...

Lumoral-tutkijasta Vuoden Suuhygienisti 2022
Suomen Suuhygienistiliitto SSHL ry:n hallitus ja P&G Professional Oral Health/ Oral-B ovat myöntäneet Vuoden Suuhygienisti 2022 -tittelin Suuhygienisti YAMK Hanna Lähteenmäelle. Lumoral-tutkija...

Puhdas suu ilman suuvesien haittavaikutuksia
Moni kokeilee pahanhajuisen hengityksen ja plakin karkottamiseksi suuvettä. Suuvedet taistelevat plakkia aiheuttavia bakteereja vastaan ja raikastavat kyllä hengityksen, mutta markkinoilla olevien ...
